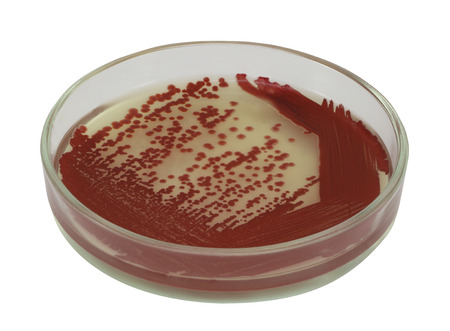

写真素材 - Red bacterial colonies on a petri dish isolated on a white background
作品情報
Red bacterial colonies on a petri dish isolated on a white background
- ID:39704667
- 作品種別:写真
- 作者名:Andrei Samkov
キーワード
- agar
- backgrounds
- bacteria
- bacteriology
- bacterium
- biological
- biology
- biotechnology
- cell
- clinic
- close up
- colonies
- colony
- color
- culture
- danger
- exam
- experiment
- glass
- growth
- health
- healthcare
- hygiene
- image
- incubate
- incubator
- isolated
- laboratory
- medical
- medicine
- medium
- micro
- microbiology
- microflora
- microorganisms
- object
- pathogen
- pathogenic
- petri
- plate
- prokaryote
- research
- risk
- safety
- sample
- science
- scientific
- strain
- strain
- test
- toxic
- unhygienic
- warning
- white
- dish
類似作品
Bacterial colon...
Selective focus...
Microbial growt...
Rusty old steel...
bacteria colony...
Red blood cells...
Bacteria and vi...
Small Jelly Fis...
Bacteria of dif...
Mold on red jui...
CLOSEUP PHOTO O...
Red bacteria on...
Bacterial and m...
Close-up of vir...
Microbiology.
imitation of ba...
Red blood cells...
Petri dish clos...
bacteria colony...
Healthy human r...
Red jellyfishes...
texture of a st...
Research of vir...
Medical Backgro...
Microbiology
Paint backgroun...
Bacteria Lactoc...
Examining Bacte...
Blood cells in ...
3d rendering ab...
Close up of men...
E. coli on diff...
Gram negative b...
Vibrio cholerae...
Old grungy crac...
Close up of gla...
Threads of fung...
red colony in p...
A high magnific...
Mould
Background with...
purple colored ...
Colonies of bac...
Beautiful elect...
Mold colonies
Medecine. A glo...
microbiology la...
translucent oil...
Vivid Represent...